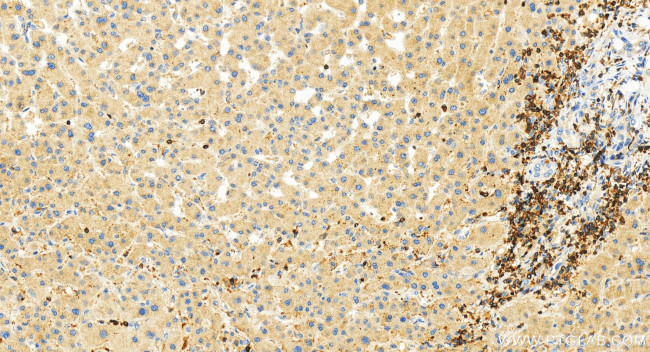
RASAL3 Antibody in Immunohistochemistry (Paraffin) (IHC (P))

Search
Proteintech
RASAL3 Polyclonal Antibody
{{$productOrderCtrl.translations['antibody.pdp.commerceCard.promotion.promotions']}}
{{$productOrderCtrl.translations['antibody.pdp.commerceCard.promotion.viewpromo']}}
{{$productOrderCtrl.translations['antibody.pdp.commerceCard.promotion.promocode']}}: {{promo.promoCode}} {{promo.promoTitle}} {{promo.promoDescription}}. {{$productOrderCtrl.translations['antibody.pdp.commerceCard.promotion.learnmore']}}
产品信息
21164-1-AP
种属反应
宿主/亚型
分类
类型
抗原
偶联物
形式
浓度
规格
纯化类型
保存液
内含物
保存条件
运输条件
产品详细信息
Immunogen sequence: VPMRLPLPPA QVHSSLSAGE KPGFLAPRDL PKHTPLISKS QSLRSVRRSE SWARPRPDEE RPLRRPRPVQ RTQSVPVRRP ARRRQSAGPW PRPKGSLSMG PAPRARPWTR DSASLPRKPS VPWQRQMDQP QDRNQALGTH RPVNKLAELQ CEVAALREEQ KVLSRLVESL STQIRALTEQ QEQLRGQLQD LDSRLRAGSS EFDSEHNLTS NEGHSLKNLE HRLNEMERTQ AQLRDAVQSL QLSPRTRGSW SQPQPLKAPC LNGDTT
靶标信息
May functions as a Ras GTPase-activating protein.
仅用于科研。不用于诊断过程。未经明确授权不得转售。
篇参考文献 (0)
生物信息学
蛋白别名: RAS protein activator like-3; unnamed protein product
基因别名: RASAL3
UniProt ID: (Human) Q86YV0
Entrez Gene ID: (Human) 64926